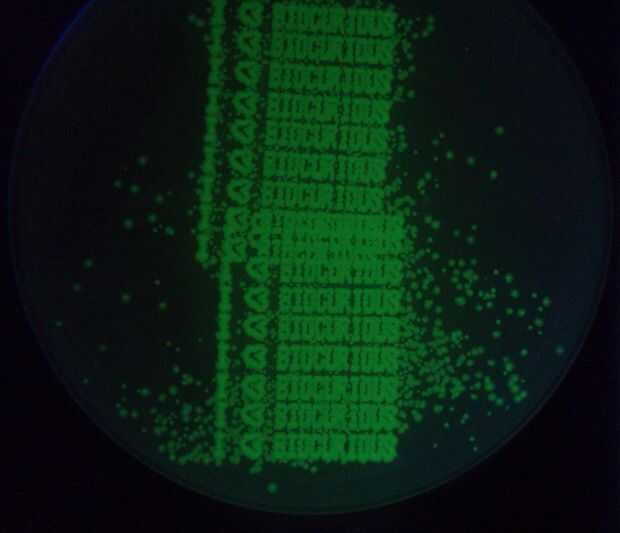

Anthony Atala: Crecer nuevos órganos
Anthony Atala: impresión de un riñón humano
Todo esto suena complejo increíble, pero el hecho es que las tecnologías básicas son muy accesibles, todo está basado en inyección de tinta o impresión 3D! Así que un montón de nosotros en el BioCurious decidió que quería jugar con esta tecnología- y nació el proyecto de la comunidad de BioPrinter! (Venga con nosotros, todos los jueves en BioCurious!)
Escribimos este instructable en parte para documentar nuestro proyecto para nuestro compañero Scientists de ciudadano en la comunidad de DIYbio , por lo que se está haciendo un poco largo. Para aquellos que quieren una introducción rápida de 1 minuto, puede que desee comprobar este pequeño video: